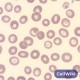
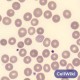
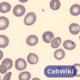
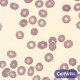

: Que celula es
: Que celula es
: Que celula es
: Que celula es
: Que celula es
: Que celula es
: Que celula es
: Que celula es
: Que celula es
: Que celula es
Otros juegos similares:
Otros juegos similares:
Otros juegos similares:























